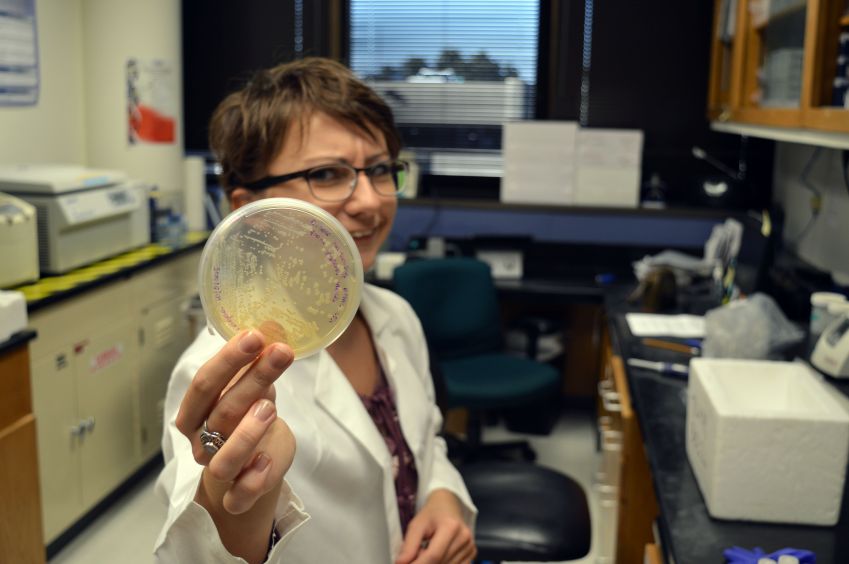

Archiwum aktualności
inż. Magdalena Sroka - studentka Biotechnologii laureatką programu Polsko-Amerykańskiej Komisji Fulbrighta
przez Edito Administrator
Pani inż. Magdalena Sroka, studentka II roku studiów magisterskich kierunku Biotechnologia, specjalność Biotechnologia molekularna jest laureatką prestiżowego programu University of Virginia-University of Chicago Visiting Research Graduate Traineeship Program for Polish Masters Students in the Biological Sciences pod patronatem Polsko-Amerykańska Komisja Fulbrighta.
Magdalena Sroka o sobie - "pracuję w Oklahoma Medical Research Foundation (https://omrf.org/) w Oklahoma City, USA. Kierownikiem mojego laboratorium jest dr Umesh Deshmukh. W ramach projektu badam mechanizm, według którego przeciwciała skierowane przeciwko białkom z rodziny TRIM mogą powodować występowanie zespołu Sjögrena - autoimmunologicznej choroby, która cechuje się uszkodzeniami gruczołów ślinowych i łzowych. Badania prowadzimy na liniach komórkowych oraz myszach, wykorzystując rekombinowane białka".